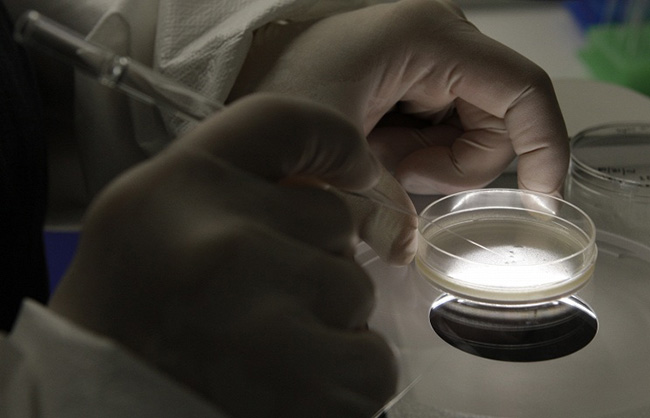

Кинези успешно уклањају дефектне гене из људских ембриона
РАДЕ НА УНИВЕРЗИТЕТУ „СУН ЈАТСЕН” – ЗАСАД УСПЕШНИ У 30 ОДСТО СЛУЧАЈЕВА
КИНЕСКИ научници извели су – како је објавио лист „Саут Чајна морнинг пост” – успешну генетску модификацију људског ембриона.
Група научника са универзитета „Сун Јатсен” успела је да „коригује” ДНК људских ембриона, односно да измене дефектни ген који би – да није био уклоњен – довео до појаве тешке наследне болести крви бета-таласемије.
Кинески научници су „редиговали” 86 ембриона које су добили од клиника. Саопштили су да им је пошло за руком да 28 (то јест – 30%) успешно ослободе дефектних гена.
У Кини се експерименти и истраживања у овој области сматрају потпуно оправданим јер се изводе на ембрионима из којих се и онако не би развио живот.




















